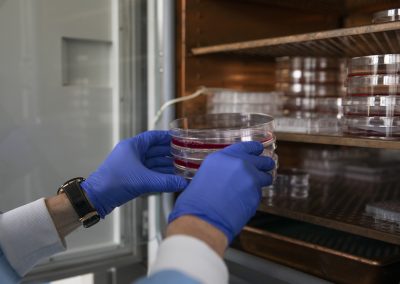

Modificaciones genéticas y cultivos celulares
Servicios Científico Técnicos
Provee de las infraestructuras, conocimientos y soporte técnico en cultivos celulares y modificaciones genéticas a la comunidad investigadora que lo requiera.
Apoyamos tanto el entrenamiento y asesoramiento de investigadores que disponen de instalaciones propias para continuar su trabajo de cultivo, como a aquellos que deseen realizar todo el trabajo de cultivo en nuestras instalaciones en el CIBA. Asimismo, cuando nuestra disponibilidad de personal lo permite, realizamos íntegramente todo el trabajo de cultivo celular que se requiera en el proyecto.
Desde esta Unidad, ofrecemos tres tipos de servicios:
- El investigador dispone de instalaciones de cultivo celular pero carece de los conocimientos técnicos: Entrenamiento y asesoramiento en técnicas de cultivo celular. Una vez finalizado el entrenamiento, el investigador realiza los cultivos en sus instalaciones.
- El investigador no dispone de instalaciones de cultivo celular y carece de los conocimientos técnicos: Entrenamiento y asesoramiento en técnicas de cultivo celular. Una vez finalizado el entrenamiento, el investigador realiza los cultivos en las instalaciones de la UCC.
- El investigador no dispone de instalaciones de cultivo celular, carece de los conocimientos técnicos y no dispone de personal para realizar los cultivos celulares: Entrenamiento y asesoramiento en técnicas de cultivo celular. Una vez finalizado el entrenamiento, el personal de la UCC realiza los cultivos en nuestras instalaciones.
Modificaciones Genéticas y Cultivos Celulares forma parte de la Plataforma de Terapias Avanzadas del IACS
Servicios
- Obtención de Cultivos Primarios de diferentes orígenes tisulares (animal y humano): aislamiento, purificación, caracterización, mantenimiento y expansión. Criopreservación de las células así obtenidas.
- Generación de líneas celulares humanas y animales embrionarias y adultas: obtención, caracterización, mantenimiento y expansión. Criopreservación de las líneas así obtenidas.
- Diferenciación inducida de células madre hacia diversos tipos celulares: cultivo de las células en presencia de diferentes medios de diferenciación que incorporan los suplementos adecuados. Identificación y caracterización de las células diferenciadas empleando técnicas de Biología Molecular y Celular.
- Técnicas de Ingeniería genética para modificación y marcaje de linajes celulares específicos: Métodos y técnicas por Biología Molecular y Celular para la caracterización de los fenotipos celulares obtenidos.
Equipamiento
- Incubadores de CO2 con sensor IR y camisa de agua. Control automático del CO2, temperatura, RH y %O2 (para incubación en hipoxia).
- Cabinas de Bioseguridad nivel II, centrífugas refrigeradas, baños de agua, electroporador, ultracongeladores y tanques de Nitrógeno Líquido en laboratorio con atmósfera controlada.
- Microscopios invertidos con contraste de fases y sistema digital de captación de imágenes.
- Irradiador de Rayos-X Faxitron X-Ray CP-160.
- Espectrofotómetro-Fluorímetro-Luminómetro Biotek Sinergy HT SIAFRD.
- Contador de partículas Beckman-Coulter Z2.
- Equipamiento básico para realización de técnicas de biología molecular y celular orientadas a la modificación y marcaje de distintos tipos celulares.
Próximos eventos de los SCT
Noticias de los SCT
Más de 40 especialistas se formarán en las instalaciones de Cirugía Experimental en el marco del Congreso de la Sociedad Española de Cirugía Plástica, Reparadora y Estética
Los talleres precongresuales de la 58ª edición de este congreso se desarrollarán en el CIBA, elegido por la organización por la sobresaliente dotación en infraestructura con la que cuenta, destacando el moderno bloque quirúrgico y la adecuada ubicación en el territorio nacional
Cuarenta especialistas se formarán en cirugía de mano y microcirugía en el CIBA
Las instalaciones de Cirugía Experimental, que comparten el IACS y la Universidad de Zaragoza en el CIBA, acogerán las prácticas del curso Micro y Mano «Pedro Marquina», que celebra este año su XXXIX edición, del 10 al 13 de marzo
Galería de imágenes
Visita virtual
Si quieres visitar más instalaciones del CIBA, accede a la visita virtual de Ciencia Abierta 24 horas.
Contacto SCT Modificaciones Genéticas y Cultivos Celulares
Centro de Investigación Biomédica de Aragón (CIBA). Planta A
Avda San Juan Bosco 13, 50009, Zaragoza
Tfno 976 71 3061(laboratorio)
ucc.iacs@aragon.es